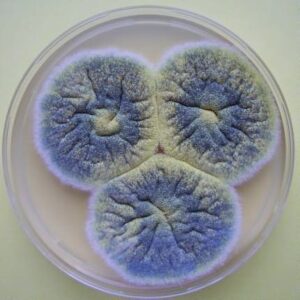

Рубрика «Пользовательские»
Идеальная кладка газобетонных блоков
Больше и больше личных застройщиков и строй компаний прибегают к использованию
Какая температура должна быть в холодильнике и в морозильной камере: стандарты и нормы
Где взять бесплатные промокоды: проверенные способы

В эпоху онлайн-шопинга промокоды стали настоящей находкой для экономных покупателей. Они позволяют получать скидки, бесплатную доставку или подарки при заказе. Разберёмся, где можно найти бесплатные и актуальные промокоды. 1. Официальные сайты и рассылки магазинов Многие компании раздают промокоды своим подписчикам: Подпишитесь на email-рассылку — часто первый промокод дают за регистрацию. Следите за акциями на официальных …
Чем накладная раковина отличается от встраиваемой
2,K Бесконечное многообразие выбора сантехнической фурнитуры для ванной комнаты может оказаться как благословением, так и проклятием. Среди этого многообразия два популярных варианта раковин — накладная и встраиваемая. Рекомендуем подробнее узнать на странице . Накладная раковина: подчеркиваем индивидуальность Данные модели устанавливаются поверх столешницы или мебельного модуля, создавая эффект плавного перехода от поверхности к раковине. Вариант отличается